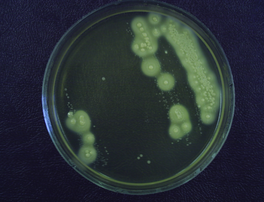

ХАРАКТЕРИСТИКА ПИТАТЕЛЬНЫХ СРЕД (830999)
Текст из файла
ХАРАКТЕРИСТИКА ПИТАТЕЛЬНЫХ СРЕД
Питательные среды применяются в микробиологической практике для выращивания различных микроорганизмов с целью диагностики инфекционных заболеваний.
Питательные среды классифицируются:
по консистенции: жидкие (бульоны) - мясо-пептонный бульон (МПБ), тиогликолевая среда; плотные (к жидкой среде добавляют 1,5-3% агара)- мясо - пептонный агар (МПА); полужидкие (0,3-0,7 % агара) – бифидум среда.
по составу: простые - МПБ, пептонная вода (ПВ), МПА - обеспечивают питательные потребности многих микроорганизмов, имеют минимум питательных веществ;
сложные (к простой среде добавляют различные компоненты: углеводы, витамины, кровь, факторы роста). Пример: кровяной агар, маннит-солевой агар (МСА), шоколадный агар.
по назначению:
элективные (специальные среды для роста микроорганизмов определенного вида, т.к. обеспечивают благоприятные условия, но задерживают или подавляют рост сопутствующих микроорганизмов)- щелочной агар для холерного вибриона, сахарный бульон для стрептококков, среда Сабуро для грибов, тиогликолевая среда для анаэробов;
дифференциально- диагностические (позволяющие отличить рост одного вида микроорганизмов от другого, определить ферментативные свойства микроорганизмов). Пример: среда Эндо, среда Плоскирева, среды Гисса, МСА, среда Сабуро).
МПА Кровяной агар
Маннит-солевой агар
Питательные среды должны соответствовать следующим требованиям:
-
Должны содержать в легко усвояемой форме все вещества, необходимые для удовлетворения пищевых и энергетических потребностей (микроэлементы, минеральные вещества, витамины, аминокислоты);
-
Быть стерильными;
-
Быть изотоничными для микробной клетки;
-
Плотные среды должны иметь оптимальную влажность, вязкость;
-
Иметь оптимальную реакцию (рН);
-
По возможности быть прозрачными.
Характеристики
Тип файла документ
Документы такого типа открываются такими программами, как Microsoft Office Word на компьютерах Windows, Apple Pages на компьютерах Mac, Open Office - бесплатная альтернатива на различных платформах, в том числе Linux. Наиболее простым и современным решением будут Google документы, так как открываются онлайн без скачивания прямо в браузере на любой платформе. Существуют российские качественные аналоги, например от Яндекса.
Будьте внимательны на мобильных устройствах, так как там используются упрощённый функционал даже в официальном приложении от Microsoft, поэтому для просмотра скачивайте PDF-версию. А если нужно редактировать файл, то используйте оригинальный файл.
Файлы такого типа обычно разбиты на страницы, а текст может быть форматированным (жирный, курсив, выбор шрифта, таблицы и т.п.), а также в него можно добавлять изображения. Формат идеально подходит для рефератов, докладов и РПЗ курсовых проектов, которые необходимо распечатать. Кстати перед печатью также сохраняйте файл в PDF, так как принтер может начудить со шрифтами.